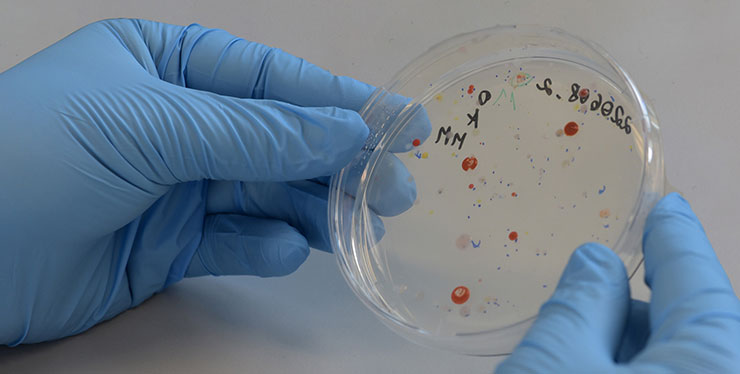
eine von zwei Händen in Schutzhandschuhen gehaltene Glasschale

Biostoffe werden durch die Biostoffverordnung definiert als:
- Mikroorganismen (insbesondere Bakterien, Viren, Pilze und Protozoen),
- Zellkulturen tierischer und pflanzlicher Herkunft,
- humanpathogene Endoparasiten,
- gentechnisch veränderte Mikroorganismen, Zellkulturen, Endoparasiten,
- Agenzien, die mit transmissibler spongioformer Enzephalopathie assoziiert sind (Prionproteine, z. B. als Erreger von BSE/Rinderwahnsinn),
- Ektoparasiten,
- technisch hergestellte, biologische Einheiten,
die bei Menschen Infektionskrankheiten sowie Erkrankungen auf Grund ihrer möglichen sensibilisierenden oder toxischen Wirkungen hervorrufen können oder sonstige gesundsschädigende Wirkungen haben.
Weiter Fachinformationen finden Sie unter Sicheres Arbeiten im Labor der Berufsgenossenschaft Rohstoffe und chemische Industrie (BG RCI).
